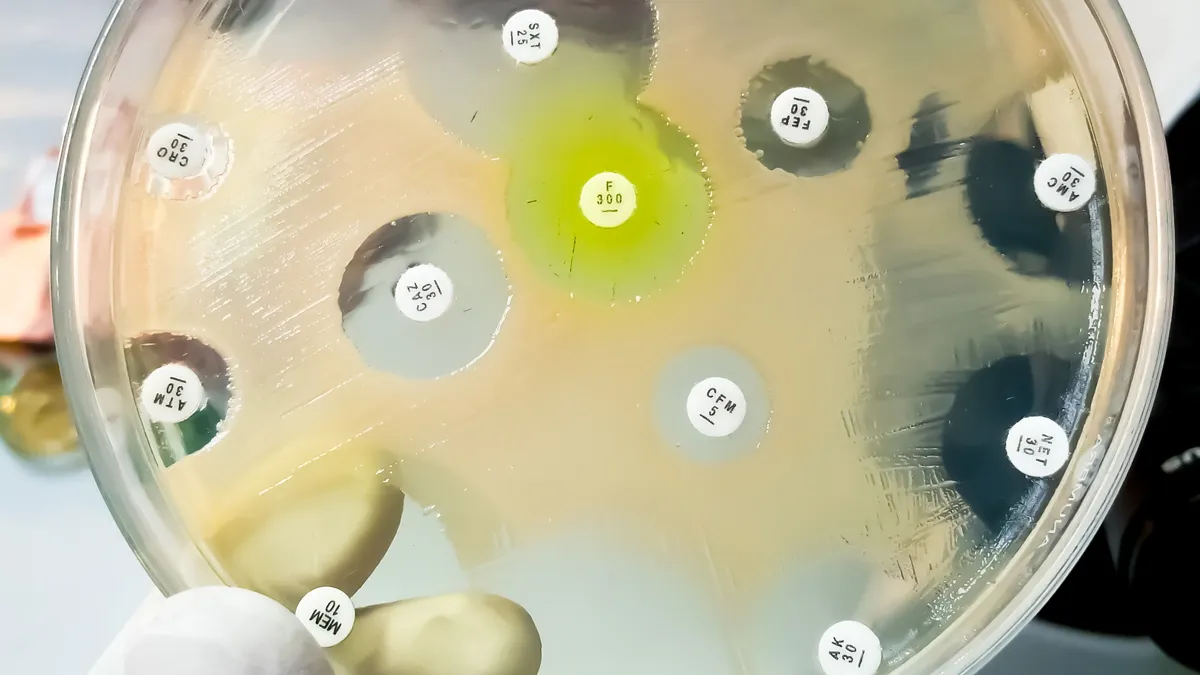
bacterieel onderzoek

Er is een nieuwe langetermijnaanpak gemaakt om de risico’s van antimicrobiële resistentie te beperken.
Met het Nationale Actieplan Antimicrobiële Resistentie 2024-2030 stelt Nederland tal van acties voor. Nederland speelt hier de rol van proactieve verbinder en partner. Niet alleen binnen de landsgrenzen, maar ook internationaal. Antimicrobiële resistentie zorgt ervoor dat infecties moeilijker te behandelen zijn, omdat micro-organismen ongevoelig zijn geworden voor antibiotica. Dit wordt ook wel de stille pandemie genoemd, omdat er wereldwijd steeds meer mensen aan resistentie overlijden en het onderwerp desondanks nauwelijks het nieuws haalt.
Het Nationale Actieplan Antimicrobiële Resistentie 2024-2030 is een gezamenlijke inzet van de ministeries van Volksgezondheid, Welzijn en Sport (VWS), Landbouw, Natuur en Voedselkwaliteit (LNV) en Infrastructuur en Waterstaat (IenW). Want antimicrobiële resistentie heeft niet alleen te maken met de volksgezondheid, maar bijvoorbeeld ook met de staat van ons water en de gezondheid van dieren en gewassen.
Het plan bouwt voort op bestaand beleid en legt extra nadruk op drie nieuwe thema’s: het versterken van de samenwerking tussen landen, het verbreden van de focus van antibiotica naar antimicrobiële middelen (dat betekent dat naast bacteriën en virussen ook dat schimmels en gisten in de aanpak worden meegenomen) en meer aandacht voor plantgezondheid en het milieu.
Minister Pia Dijkstra: “Ook al staat ons land er relatief goed voor, het is belangrijk verder te kijken dan onze eigen grenzen. We hebben in de coronapandemie gezien hoe razendsnel infecties zich kunnen verspreiden door internationaal reizigersverkeer en onze prominente positie als handelsland. Daarnaast heeft klimaatverandering een wereldwijde impact en kan deze bijdragen aan een toename in antimicrobiële resistentie. In combinatie met het achterblijven van de ontwikkeling van nieuwe antibiotica, is dat echt een wake-up call om intensief samen te blijven werken met andere landen en actief te blijven zoeken naar oplossingen.”
Antimicrobiële resistentie vormt een ernstige bedreiging voor de volksgezondheid wereldwijd en is door de Wereldgezondheidsorganisatie (WHO) als één van de belangrijkste grensoverschrijdende gezondheidsdreigingen genoemd. Er sterven jaarlijks meer dan 700.000 mensen wereldwijd als direct gevolg van antimicrobiële resistentie. De strijd tegen deze resistentie moet daarom bovenaan de wereldwijde volksgezondheidsagenda blijven staan.
Te veel en onjuist gebruik van antibiotica bij mens en dier, en in gewasbeschermingsmiddelen en de industrie zorgt daarnaast onnodig voor resistentie. Een extra zorgwekkend signaal is dat resistentie tegen belangrijke antimicrobiële middelen op dit moment sneller toeneemt dan dat nieuwe middelen ontwikkeld worden.
Het Actieplan is erop gericht om voor de lange termijn negatieve effecten van resistente micro-organismen voor mensen, dieren en planten (in Nederland, maar ook internationaal) zoveel mogelijk tegen te gaan. Nederland heeft in deze aanpak – dit wordt de One Health aanpak genoemd - wereldwijd een belangrijke positie. Zo heeft de Nederlandse veehouderij, in de periode van 2009 tot 2021, het gebruik van antibiotica met ongeveer 77 procent verminderd.
Voor de komende zes jaar staan in totaal 104 acties gepland. Zo wordt de komende vier jaar nauw samengewerkt met andere Europese landen in een groot One Health project dat lidstaten ondersteunt bij het uitvoeren van hun antimicrobiële resistentie beleid.






